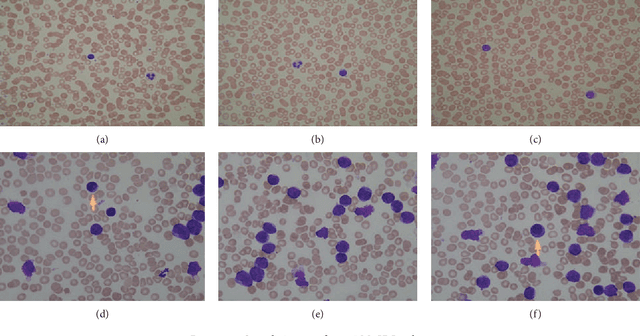
Figure 1 for Robust Method for Semantic Segmentation of Whole-Slide Blood Cell Microscopic Image

Abstract:Previous works on segmentation of SEM (scanning electron microscope) blood cell image ignore the semantic segmentation approach of whole-slide blood cell segmentation. In the proposed work, we address the problem of whole-slide blood cell segmentation using the semantic segmentation approach. We design a novel convolutional encoder-decoder framework along with VGG-16 as the pixel-level feature extraction model. -e proposed framework comprises 3 main steps: First, all the original images along with manually generated ground truth masks of each blood cell type are passed through the preprocessing stage. In the preprocessing stage, pixel-level labeling, RGB to grayscale conversion of masked image and pixel fusing, and unity mask generation are performed. After that, VGG16 is loaded into the system, which acts as a pretrained pixel-level feature extraction model. In the third step, the training process is initiated on the proposed model. We have evaluated our network performance on three evaluation metrics. We obtained outstanding results with respect to classwise, as well as global and mean accuracies. Our system achieved classwise accuracies of 97.45%, 93.34%, and 85.11% for RBCs, WBCs, and platelets, respectively, while global and mean accuracies remain 97.18% and 91.96%, respectively.